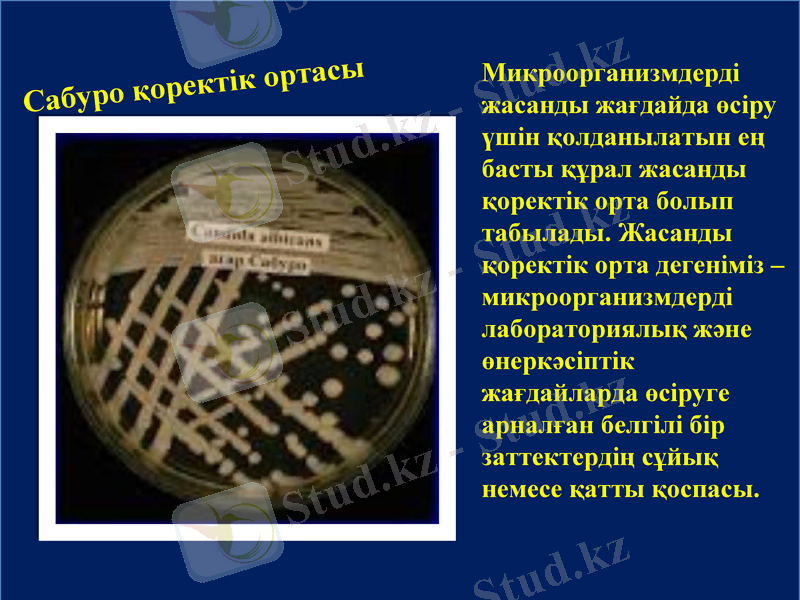
Slide 3
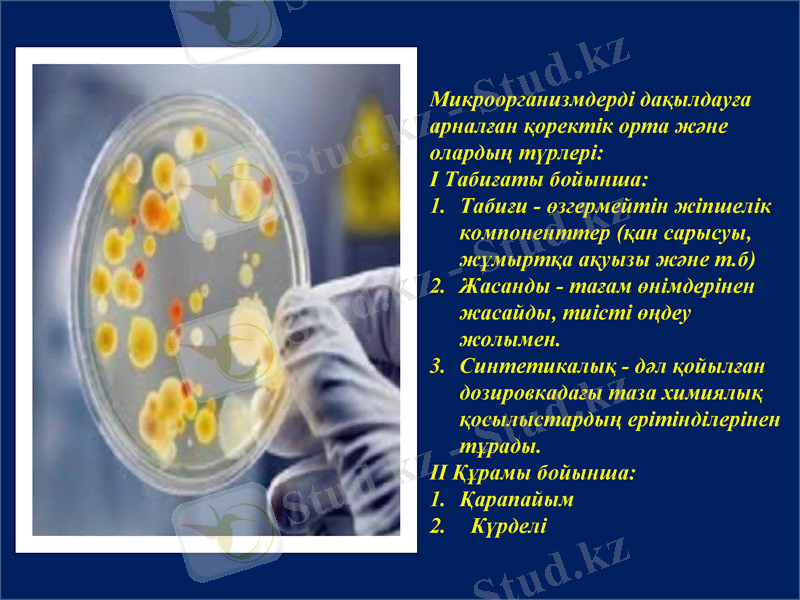
Slide 4
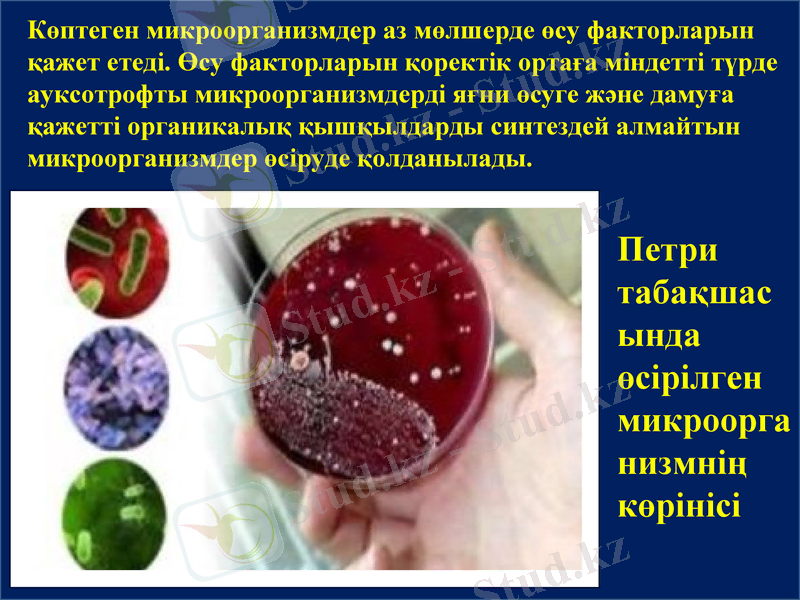
Slide 7
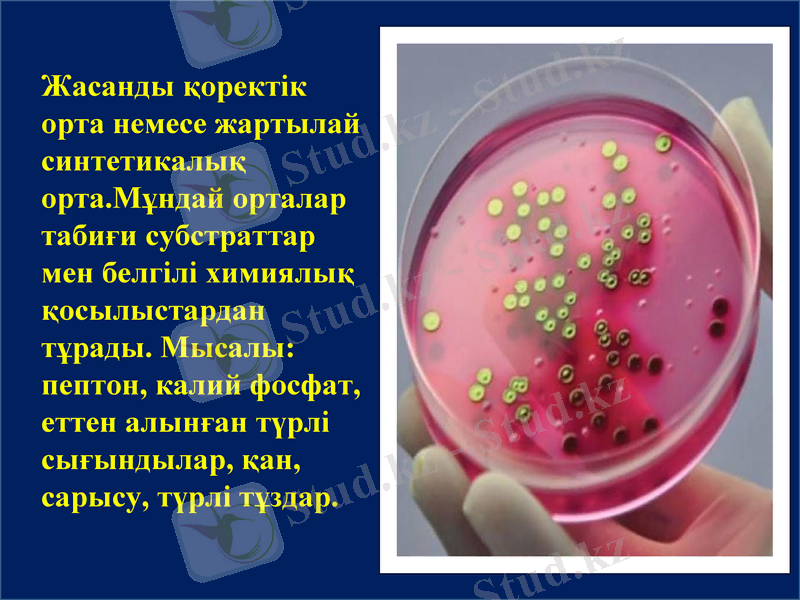
Slide 8
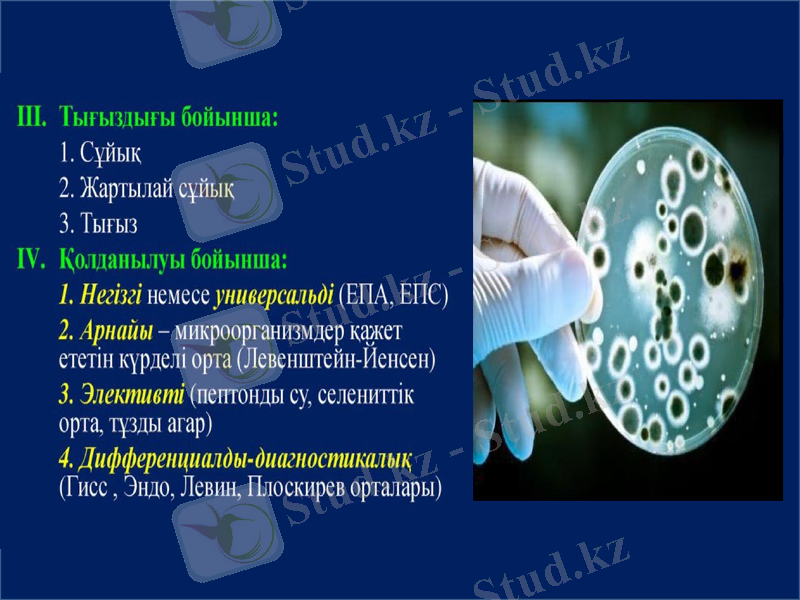
Slide 10

Микроорганизмдерді жасанды қоректік орталарда өсіру: түрлері мен әдістері



А. Байтұрсынов атындағы Қостанай өңірлік университеті
Презентация
Тақырып: Микроорганизмдерді жасанды жағдайда өсіру. Өсіру әдістері
Орындаған: Сеитов Б. А.
Сарыбай Д. Б.
Қабылдаған:Амирбекова Н. А.
Тобы: 18-700-42

Жоспар
Кіріспе
Микроорганизмдерді өсірудегі жасанды қоректік орта
Негізгі бөлім
1. Микроорганизмдерді дақылдауға арналған қоректік орта және олардың түрлері
2. Жасанды қоректік орталардың жіктелуі
3. Өсіру әдістері
Қорытынды
Пайдаланылған әдебиеттер
Сабуро қоректік ортасы
Микроорганизмдерді жасанды жағдайда өсіру үшін қолданылатын ең басты құрал жасанды қоректік орта болып табылады. Жасанды қоректік орта дегеніміз - микроорганизмдерді лабораториялық және өнеркәсіптік жағдайларда өсіруге арналған белгілі бір заттектердің сұйық немесе қатты қоспасы.
Микроорганизмдерді дақылдауға арналған қоректік орта және олардың түрлері:
І Табиғаты бойынша:
Табиғи - өзгермейтін жіпшелік компоненттер (қан сарысуы, жұмыртқа ақуызы және т. б)
Жасанды - тағам өнімдерінен жасайды, тиісті өңдеу жолымен.
Синтетикалық - дәл қойылған дозировкадағы таза химиялық қосылыстардың ерітінділерінен тұрады.
ІІ Құрамы бойынша:
Қарапайым
Күрделі

Табиғи қоректік орта - құрамы белгісіз табиғи субстраттар негізінде жасалады.
Табиғи орта түрлері: сүт, жұмыртқа, көң, ет, топырақ, балық, тағамдық өсімдіктер, экстракттар, шырындар және т. б табиғи заттар жатады.

Петри табақшалары
Микроорганизмдер қажет ететін қоректік орталардың әртүрлілігі және олардың клетканың басты компоненттерін синтездеуде, өсуі, көбеюі және энергия алуда қолданылуын Қоректік қосылыстар деп, ал құрамы қоректік қосылыстардан тұратын ортаны Қоректік орта деп атайды.
Петри табақшасында өсірілген микроорганизмнің көрінісі
Көптеген микроорганизмдер аз мөлшерде өсу факторларын қажет етеді. Өсу факторларын қоректік ортаға міндетті түрде ауксотрофты микроорганизмдерді яғни өсуге және дамуға қажетті органикалық қышқылдарды синтездей алмайтын микроорганизмдер өсіруде қолданылады.
Жасанды қоректік орта немесе жартылай синтетикалық орта. Мұндай орталар табиғи субстраттар мен белгілі химиялық қосылыстардан тұрады. Мысалы: пептон, калий фосфат, еттен алынған түрлі сығындылар, қан, сарысу, түрлі тұздар.

Синтетикалық қоректік орта - белгілі концентрацияда нақты химиялық қосылыстар негізінде жасалады. Олардың құрамы микроорганизмдердің қоректік заттарға деген қажеттілігіне байланысты болады.

Жасанды қоректік орталардың жіктелуі
Консистенциясына байланысты:
Сұйық
Жартылай сұйық(агар 0, 5%)
Тығыз(агар1, 5-2%)

Жасанды қоректік орталардың жіктелуі
Құрамына байланысты
- Табиғи
қарапайым
- ет пептонды агар және сорпа (ЕПА ж/е ЕПС)
- желатин
- сүт
- жемістердің бөліктері
Күрделі
қарапайым+қоспалар
- Синтетикалық

Почему?
Қорытынды
Бактерияларды қоректік ортаға енгізгеннен кейін микроорганизмдер қарқынды өсе бастайды. Өсу кезінде қоректік ортада қажетті компаненттердің мөлшері минимумға жеткенде өсу тоқтатылады. Егер осы аралықта қоректік заттармен орта қамтамасыз етілмесе және зат алмасу нәтижесінде түзілген соңғы өнімдер алынбаса, онда периодты дақыл алынады.

Пайдаланылған әдебиеттер тізімі
Шигаева М. Х. , Қанаев А. Т. «Микробиология және вирусология»
2. Цзю В. Л. , Шигаева М. Х. «Микробиология»
Кирбаева Д. К. «Микробиология және вирусология негіздері»
4. Ғаламтор желісі)

Назарларыңызға рахмет
- Іс жүргізу
- Автоматтандыру, Техника
- Алғашқы әскери дайындық
- Астрономия
- Ауыл шаруашылығы
- Банк ісі
- Бизнесті бағалау
- Биология
- Бухгалтерлік іс
- Валеология
- Ветеринария
- География
- Геология, Геофизика, Геодезия
- Дін
- Ет, сүт, шарап өнімдері
- Жалпы тарих
- Жер кадастрі, Жылжымайтын мүлік
- Журналистика
- Информатика
- Кеден ісі
- Маркетинг
- Математика, Геометрия
- Медицина
- Мемлекеттік басқару
- Менеджмент
- Мұнай, Газ
- Мұрағат ісі
- Мәдениеттану
- ОБЖ (Основы безопасности жизнедеятельности)
- Педагогика
- Полиграфия
- Психология
- Салық
- Саясаттану
- Сақтандыру
- Сертификаттау, стандарттау
- Социология, Демография
- Спорт
- Статистика
- Тілтану, Филология
- Тарихи тұлғалар
- Тау-кен ісі
- Транспорт
- Туризм
- Физика
- Философия
- Халықаралық қатынастар
- Химия
- Экология, Қоршаған ортаны қорғау
- Экономика
- Экономикалық география
- Электротехника
- Қазақстан тарихы
- Қаржы
- Құрылыс
- Құқық, Криминалистика
- Әдебиет
- Өнер, музыка
- Өнеркәсіп, Өндіріс
Қазақ тілінде жазылған рефераттар, курстық жұмыстар, дипломдық жұмыстар бойынша біздің қор #1 болып табылады.



Ақпарат
Қосымша
Email: info@stud.kz